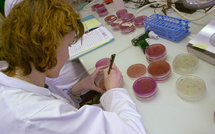
Listériose: 12 cas, dont 2 mortels, en lien avec des charcuteries d'une entreprise de la Drôme

|
Actualité de France
L'information de la métropole et de l'outremer
Paris, France | AFP | lundi 16/03/2026 - Au lendemain d'un vote marqué par la percée de La France insoumise et des scores favorables au Rassemblement...
Six nations: le XV de France bat l'Angleterre 48-46 et remporte un deuxième Tournoi d'affilée 14/03/2026
Tahiti le 14 mars 2026. Faute de Grand chelem, abandonné il y une semaine en Ecosse, le XV de France a conservé son titre en s'imposant à la dernière...
Saint-Denis de La Réunion, France | AFP | vendredi 12/03/2026 - Deux coulées de lave expulsées par le Piton de la Fournaise, volcan en éruption...
Paris, France | AFP | vendredi 13/03/2026 - La campagne pour le premier tour des élections municipales entre vendredi dans son dernier jour, avec une...
Paris, France | AFP | vendredi 13/03/2026 - Emmanuel Macron, en recevant Volodymyr Zelensky à l'Elysée, a affirmé vendredi que la Russie "se trompe"...
Paris, France | AFP | jeudi 12/03/2026 - Un million de modems infectés, des ramifications des deux côtés de l'Atlantique: une opération...
Paris, France | AFP | vendredi 13/03/2026 - Un militaire français a été tué et six blessés jeudi soir dans une attaque de drone dans la région...
Nice, France | AFP | jeudi 12/03/2026 - Le duel entre Christian Estrosi et Eric Ciotti à Nice s'annonçait sans merci mais l'enquête sur la tête de...
Listériose: 12 cas, dont 2 mortels, en lien avec des charcuteries d'une entreprise de la Drôme 12/03/2026
Paris, France | AFP | jeudi 12/03/2026 - Douze cas de listériose ont été identifiés entre septembre et janvier liés à des charcuteries d'une...
Paris, France | AFP | jeudi 12/03/2026 - Air France et KLM ont augmenté leurs tarifs sur les trajets long-courriers face à la flambée pétrolière...
|
||||
|
TAHITI-INFOS est un site édité par FENUACOMMUNICATION Sarl au capital de 20 000 000 Fcfp, immeuble Manarava - Shell RDO Faa'a - BP 40160 98 713 Papeete Polynésie Française.
(+689) 40 43 49 49 - Dir. de publication : Sarah MOUX - Gérant : Albert MOUX |
||||